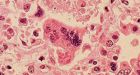
As many as 100 kids in Fraser Valley, B.C. may have measles | CTV News

Also see the CKA News Wall
NEWS IMAGE COLLAGE / for 03-2014
 Greenpeace activists arrested in French nuclear break-in
Greenpeace activists arrested in French nuclear break-in
French police arrested 34 Greenpeace activists on Tuesday who forced their way into a nuclear power plant operated by EDF in Fessenheim, eastern France, the company said.
| Posted: | 1:13 PM on Tuesday |
| Topic: | Law & Order |
| Hits: | 206738 |
| Rating: | 20674 |
| Poster: | N_Fiddledog |

A new report from Statistics Canada is raising questions about the seriousness of what the Conservative government says is a major national problem
| Posted: | 12:35 PM on Tuesday |
| Topic: | Political |
| Hits: | 206743 |
| Rating: | 20674 |
| Poster: | DrCaleb |
 March against police brutality declared illegal, broken up
March against police brutality declared illegal, broken up
| Posted: | 7:13 AM on Tuesday |
| Topic: | Law & Order |
| Hits: | 206708 |
| Rating: | 20671 |
| Poster: | DrCaleb |
 'Fireball' in sky over Maritime Canada seen by dozens
'Fireball' in sky over Maritime Canada seen by dozens
A bright light that looked like a fireball lit up the whole northern sky over Canada's Maritime provinces early this morning, callers to CBC morning shows report.
| Posted: | 7:08 AM on Tuesday |
| Topic: | Misc CDN |
| Hits: | 206827 |
| Rating: | 20684 |
| Poster: | DrCaleb |
 W.D. Hamilton's evolutionary theory driving world-changing research
W.D. Hamilton's evolutionary theory driving world-changing research
The scientific community is commemorating the work of W.D. Hamilton, who pioneered the idea that everything from bees' behaviour to the way cancer spreads in the body can be explained by evolution.
| Posted: | 7:08 AM on Tuesday |
| Topic: | Science |
| Hits: | 206831 |
| Rating: | 20683 |
| Poster: | DrCaleb |
 Last of Canadian soldiers in Afghanistan return home | CTV News
Last of Canadian soldiers in Afghanistan return home | CTV News
The last group of Canadian soldiers serving in Afghanistan has returned home. The troops arrived in Ottawa Tuesday morning on a military transport plane escorted by fighter jets.
| Posted: | 6:45 AM on Tuesday |
| Topic: | Military |
| Hits: | 207029 |
| Rating: | 20704 |
| Poster: | DrCaleb |
 Canucks' chances for playoff spot near zero
Canucks' chances for playoff spot near zero
Steven Stamkos and Ondrej Palat both had a goal and an assist to lead the Lightning past the Vancouver Canucks 4-3 on Monday night.
| Posted: | 12:47 AM on Tuesday |
| Topic: | Sports |
| Hits: | 206710 |
| Rating: | 20671 |
| Poster: | Hyack |
 California's debt half of Ontario's
California's debt half of Ontario's
TORONTO -- Ontario's debt is nearly double that of California's -- even though the province has far fewer people and a much smaller economy, the Fraser Institute says.
| Posted: | 10:37 PM on Monday |
| Topic: | Business |
| Hits: | 207119 |
| Rating: | 20712 |
| Poster: | N_Fiddledog |
 Dolphins, orcas delight watchers in Vancouver, Squamish
Dolphins, orcas delight watchers in Vancouver, Squamish
If you kept a close eye on the waters near Vancouver and Squamish this weekend, you may have seen the dolphins and even some orcas.
| Posted: | 7:25 PM on Monday |
| Topic: | Misc CDN |
| Hits: | 206932 |
| Rating: | 20694 |
| Poster: | Hyack |
 4,400 cans of beer seized from Waterloo, Ont. home
4,400 cans of beer seized from Waterloo, Ont. home
Ontario Provincial Police seized 4,400 cans of beer from a Waterloo, Ont. home on Sunday morning, ahead of a St. Patrick's Day party.
| Posted: | 5:27 PM on Monday |
| Topic: | Misc CDN |
| Hits: | 206972 |
| Rating: | 20697 |
| Poster: | Hyack |
 Los Angeles wakes up to 4.4 magnitude earthquake
Los Angeles wakes up to 4.4 magnitude earthquake
A pre-dawn earthquake rolled across the Los Angeles basin on Monday, rattling residents from the San Fernando Valley to Long Beach but causing no reported damage.
| Posted: | 5:23 PM on Monday |
| Topic: | Misc World |
| Hits: | 206725 |
| Rating: | 20673 |
| Poster: | Hyack |
 Man charged after dog dragged behind truck
Man charged after dog dragged behind truck
A Vars man is facing charges of animal cruelty after allegedly tying a dog to a truck and dragging him for one kilometre.
| Posted: | 5:21 PM on Monday |
| Topic: | Law & Order |
| Hits: | 206790 |
| Rating: | 20679 |
| Poster: | Hyack |
 Military action might be needed against Russia, MP Rob Anders says
Military action might be needed against Russia, MP Rob Anders says
| Posted: | 5:20 PM on Monday |
| Topic: | Misc World |
| Hits: | 206674 |
| Rating: | 20667 |
| Poster: | Hyack |
 ER overcrowding prompts nurses to quit Royal Columbian Hospital
ER overcrowding prompts nurses to quit Royal Columbian Hospital
The overcrowding at Royal Columbian Hospital in New Westminster, B.C., has become so bad nurses are quitting the emergency room according to the B.C. Nurses Union.
| Posted: | 5:17 PM on Monday |
| Topic: | Health |
| Hits: | 206853 |
| Rating: | 20685 |
| Poster: | Hyack |
 U of Regina cheerleaders in hot water for cowboys and Indians event
U of Regina cheerleaders in hot water for cowboys and Indians event
The University of Regina's administration has apologized after the school's cheerleaders planned a "culturally inappropriate" cowboys and Indians night.
| Posted: | 12:17 PM on Monday |
| Topic: | Lifestyle |
| Hits: | 207154 |
| Rating: | 20715 |
| Poster: | N_Fiddledog |

| Posted: | 8:52 AM on Monday |
| Topic: | Provincial Politics |
| Hits: | 207064 |
| Rating: | 20706 |
| Poster: | JaredMilne |
 'No one can stop' a Quebec nation from using the loonie: Duceppe
'No one can stop' a Quebec nation from using the loonie: Duceppe
'No one can stop Quebec from using the Canadian dollar,' said former Bloc Quebecois leader Gilles Duceppe in an interview that aired Sunday on CTV's Question Period.
| Posted: | 6:53 AM on Monday |
| Topic: | Political |
| Hits: | 206924 |
| Rating: | 20692 |
| Poster: | QBall |
 Accused pimp says teen girls were willing sex partners
Accused pimp says teen girls were willing sex partners
Accused pimp Reza Moazami has denied raping the underage prostitutes he worked with, claiming the sex was consensual and he believed them all to be older than 18.
| Posted: | 12:23 AM on Monday |
| Topic: | Law & Order |
| Hits: | 207036 |
| Rating: | 20704 |
| Poster: | N_Fiddledog |
 North Korea "defensively" test-fires 25 short-range rockets
North Korea "defensively" test-fires 25 short-range rockets
North Korea fired 25 short-range rockets into the sea off its east coast Sunday in an apparent continuation of protests against ongoing U.S.-South Korean military drills, South Korean officials said.
| Posted: | 7:52 PM on Sunday |
| Topic: | Misc World |
| Hits: | 207562 |
| Rating: | 20756 |
| Poster: | Public_Domain |

As more environmentally conscious Americans do their bit to help clear the air by paying up for an eco-friendly Prius or a sporty Tesla, a damaging form of polluted rain is falling in China
| Posted: | 4:46 PM on Sunday |
| Topic: | Environmental |
| Hits: | 206802 |
| Rating: | 20680 |
| Poster: | N_Fiddledog |
 BBC bans Jesus from Radio 2
BBC bans Jesus from Radio 2
| Posted: | 10:50 AM on Sunday |
| Topic: | Business |
| Hits: | 207067 |
| Rating: | 20707 |
| Poster: | N_Fiddledog |
 Criticising Islam, gays sets army major up for a fall
Criticising Islam, gays sets army major up for a fall
Major Bernie Gaynor jnr has served three tours of duty in Iraq but he is going to be thrown out of the army very soon. And he is not going quietly, writes Paul Sheehan.
| Posted: | 9:46 AM on Sunday |
| Topic: | Military |
| Hits: | 207161 |
| Rating: | 20716 |
| Poster: | N_Fiddledog |
 Opinion: lobbying government for hedge funds
Opinion: lobbying government for hedge funds
| Posted: | 9:18 AM on Sunday |
| Topic: | Business |
| Hits: | 206695 |
| Rating: | 20670 |
| Poster: | N_Fiddledog |
 Canadian hospitals stretched as self-harming teens seek help
Canadian hospitals stretched as self-harming teens seek help
Mental health services are strained as a growing number of teens show up at emergency rooms across Canada with self-inflicted injuries and suicidal thoughts, say pediatric psychiatrists.
| Posted: | 8:07 AM on Sunday |
| Topic: | Health |
| Hits: | 206814 |
| Rating: | 20681 |
| Poster: | wildrosegirl |
 Maple Leaf Foods 'disturbed' by supplier turkey farm video, promises action
Maple Leaf Foods 'disturbed' by supplier turkey farm video, promises action
| Posted: | 8:06 AM on Sunday |
| Topic: | Business |
| Hits: | 206951 |
| Rating: | 20695 |
| Poster: | wildrosegirl |
 Hockeyville Top 4 communites announced
Hockeyville Top 4 communites announced
Voting is officially open for the top 4 communities in the running to be crowned Kraft Hockeyville in 2014.
| Posted: | 8:05 AM on Sunday |
| Topic: | Sports |
| Hits: | 206719 |
| Rating: | 20672 |
| Poster: | wildrosegirl |
 Lake Louise avalanche leaves father, son dead
Lake Louise avalanche leaves father, son dead
A father and son have been killed in an avalanche in Lake Louise, Alta. Police say a Parks Canada dog handler found the victims buried under debris at the base of Mount Fairview.
| Posted: | 8:03 AM on Sunday |
| Topic: | Misc CDN |
| Hits: | 206679 |
| Rating: | 20668 |
| Poster: | wildrosegirl |
 MLSE wants $10 million from Toronto for BMO Field makeover
MLSE wants $10 million from Toronto for BMO Field makeover
Toronto is being asked for $10 million toward a BMO field makeover that would move the Toronto Argonauts back to Exhibition Place.
| Posted: | 8:21 PM on Saturday |
| Topic: | Business |
| Hits: | 206865 |
| Rating: | 20687 |
| Poster: | BeaverFever |
 Egypt destroys 1,370 Gaza smuggling tunnels
Egypt destroys 1,370 Gaza smuggling tunnels
Announcement from the military comes as ties between Cairo and Hamas deteriorate
| Posted: | 4:03 PM on Saturday |
| Topic: | Misc World |
| Hits: | 206666 |
| Rating: | 20667 |
| Poster: | N_Fiddledog |
 Gaza power plant shuts down for 'lack of fuel'
Gaza power plant shuts down for 'lack of fuel'
Palestinians say facility shuttered due to Israeli closure of crossings following this week's rocket attacks
| Posted: | 4:00 PM on Saturday |
| Topic: | Misc World |
| Hits: | 206782 |
| Rating: | 20678 |
| Poster: | N_Fiddledog |
 News from The Associated Press
News from The Associated Press
MOSCOW (AP) -- This is Ukraine today, at least as seen by most Russian news media: the government is run by anti-Semitic fascists, people killed in protests were shot by opposition snipers and the West is behind it all.
| Posted: | 3:50 PM on Saturday |
| Topic: | Political |
| Hits: | 206721 |
| Rating: | 20672 |
| Poster: | N_Fiddledog |
 Wyoming welder faces $75,000 a day in EPA fines for building pond on his property
Wyoming welder faces $75,000 a day in EPA fines for building pond on his property
Wyoming resident Andy Johnson says he's being threatened with thousands of dollars in EPA fines for building a stock pond on his property.
| Posted: | 3:32 PM on Saturday |
| Topic: | Business |
| Hits: | 206922 |
| Rating: | 20692 |
| Poster: | N_Fiddledog |
 Eurosceptic party leads in Danish poll before European election
Eurosceptic party leads in Danish poll before European election
COPENHAGEN (Reuters) - The far-right, euro-skeptic Danish People's Party may emerge as Denmark's biggest vote getter at the European parliamentary elections in May, a poll indicated on Saturday.The People's
| Posted: | 1:38 PM on Saturday |
| Topic: | Political |
| Hits: | 206728 |
| Rating: | 20673 |
| Poster: | N_Fiddledog |
 Canada wins 3rd straight wheelchair curling gold
Canada wins 3rd straight wheelchair curling gold
Canada's wheelchair curling team defeated arch-rival Russia 8-3 on Saturday to win its third straight Paralympic gold medal.
| Posted: | 9:28 AM on Saturday |
| Topic: | Sports |
| Hits: | 206753 |
| Rating: | 20676 |
| Poster: | wildrosegirl |
 Corporate tax avoidance 'scheme' hurting Canada, expert says
Corporate tax avoidance 'scheme' hurting Canada, expert says
While average Canadians dutifully file personal income tax returns during the coming weeks, many profitable companies pay little or no tax, says the executive director of Canadians for Tax Fairness. Instead, these multinational corporations set up subsidi
| Posted: | 7:30 AM on Saturday |
| Topic: | Economics |
| Hits: | 207371 |
| Rating: | 20738 |
| Poster: | wildrosegirl |
 N.B. 1st Atlantic province to sign Canada Job Grant agreement
N.B. 1st Atlantic province to sign Canada Job Grant agreement
The New Brunswick government has become the first Atlantic province to sign an agreement with Ottawa on the controversial Canada Job Grant.
| Posted: | 7:28 AM on Saturday |
| Topic: | Business |
| Hits: | 206821 |
| Rating: | 20682 |
| Poster: | wildrosegirl |
 Uranium hexaflouride being moved after crews return to work
Uranium hexaflouride being moved after crews return to work
Workers at Ceres container terminal in north-end Halifax returned to work Saturday morning after experts confirmed no radiation had leaked out of four canisters that were dropped.
| Posted: | 7:23 AM on Saturday |
| Topic: | Misc CDN |
| Hits: | 206644 |
| Rating: | 20664 |
| Poster: | wildrosegirl |
 Royal Bank accused by FDIC in LIBOR fixing lawsuit
Royal Bank accused by FDIC in LIBOR fixing lawsuit
Canada's largest bank has been named in a lawsuit initiated by a top U.S. banking regulator that accuses RBC and more than a dozen of the world's largest banks of colluding to fix a key international lending rate.
| Posted: | 7:22 AM on Saturday |
| Topic: | Business |
| Hits: | 206736 |
| Rating: | 20674 |
| Poster: | wildrosegirl |
 Sneaking repaired classic car into Canada costs man $55K
Sneaking repaired classic car into Canada costs man $55K
A Nova Scotia man was fined more than $55,000 for not declaring repairs to a 1967 Chevrolet Chevelle Malibu he had fixed in the U.S. then brought back to Canada.
| Posted: | 7:20 AM on Saturday |
| Topic: | Misc CDN |
| Hits: | 206993 |
| Rating: | 20700 |
| Poster: | wildrosegirl |
 Bearspaw student strangled by lanyard prompts $17M lawsuit
Bearspaw student strangled by lanyard prompts $17M lawsuit
A multimillion-dollar lawsuit has been launched by the parents of a student who almost died after being strangled by a lanyard at his school in Bearspaw just west of Calgary.
| Posted: | 7:19 AM on Saturday |
| Topic: | Misc CDN |
| Hits: | 207095 |
| Rating: | 20710 |
| Poster: | wildrosegirl |
 Shoe may belong to Jeffrey Boucher, missing teacher from Whitby, Ont.
Shoe may belong to Jeffrey Boucher, missing teacher from Whitby, Ont.
Police have found a shoe they believe may belong to Jeffrey Boucher, the Whitby, Ont., teacher missing since January.
| Posted: | 7:18 AM on Saturday |
| Topic: | Misc CDN |
| Hits: | 206744 |
| Rating: | 20674 |
| Poster: | wildrosegirl |
 Ottawa man charged in stabbing of Russian diplomat
Ottawa man charged in stabbing of Russian diplomat
Ottawa police charged a 32-year-old Ottawa man on Saturday in connection with the stabbing of a Russian diplomat near his country's embassy.
| Posted: | 7:16 AM on Saturday |
| Topic: | Law & Order |
| Hits: | 206753 |
| Rating: | 20675 |
| Poster: | wildrosegirl |
 Mac Marcoux wins gold in Paralympic giant slalom
Mac Marcoux wins gold in Paralympic giant slalom
The youngest member of the Canadian Paralympic team strikes gold in Sochi in his final alpine event. Mac Marcoux wins the men's visually impaired giant slalom by more than two seconds.
| Posted: | 6:51 AM on Saturday |
| Topic: | Sports |
| Hits: | 206736 |
| Rating: | 20674 |
| Poster: | wildrosegirl |
 Canada captures sledge hockey bronze!
Canada captures sledge hockey bronze!
The Canadian men's sledge hockey team shook off its semifinal loss with a 3-0 win over Norway to take the bronze medal at the 2014 Paralympics on Saturday.
| Posted: | 6:50 AM on Saturday |
| Topic: | Sports |
| Hits: | 206665 |
| Rating: | 20667 |
| Poster: | wildrosegirl |
 Belgium bans sexist insults | Mail Online
Belgium bans sexist insults | Mail Online
Mocking a stay-at-home father or insulting a woman for wearing revealing clothes will be illegal in Belgium under sexism laws unveiled yesterday.
| Posted: | 4:30 PM on Friday |
| Topic: | Lifestyle |
| Hits: | 207505 |
| Rating: | 20751 |
| Poster: | N_Fiddledog |
 Marois tries to quash sovereignty issue
Marois tries to quash sovereignty issue
| Posted: | 3:52 PM on Friday |
| Topic: | Provincial Politics |
| Hits: | 206997 |
| Rating: | 20700 |
| Poster: | JaredMilne |
 Steak And BJ Day Makes Us Want To Gag
Steak And BJ Day Makes Us Want To Gag
Today is Steak and BJ Day, and we're all out of steak. This is the so-called anti-Valentine's Day, set a month after the lovey-dovey consumer fest -- at least by all the dudes lying on Facebook and Twitter. And let's just assume all their girlfriends are
| Posted: | 1:26 PM on Friday |
| Topic: | Strange |
| Hits: | 207504 |
| Rating: | 20750 |
| Poster: | Zipperfish |
 Radical right group eyes power in Ukraine
Radical right group eyes power in Ukraine
Demonized by Russia, Right Sector denies its symbols resemble the swastika; says Jews, ethnic Russian should enjoy equal rights
| Posted: | 1:24 PM on Friday |
| Topic: | Misc World |
| Hits: | 206645 |
| Rating: | 20665 |
| Poster: | N_Fiddledog |
 Mumbai building collapse kills 7, injures 8
Mumbai building collapse kills 7, injures 8
An old, seven-story residential building collapsed Friday in a Mumbai suburb, killing at least seven people and injuring another eight, police said.
| Posted: | 12:05 PM on Friday |
| Topic: | Misc World |
| Hits: | 206599 |
| Rating: | 20660 |
| Poster: | DrCaleb |
 Federal investigators en route to Halifax port after radiation scare
Federal investigators en route to Halifax port after radiation scare
Fire officials say an evacuation zone remained in place Friday at a port in Halifax after four steel cylinders carrying weapons-grade uranium fell about six metres the night before as they were being unloaded from a container ship, prompting a radiation s
| Posted: | 11:10 AM on Friday |
| Topic: | Misc CDN |
| Hits: | 206723 |
| Rating: | 20672 |
| Poster: | Strutz |
 Working 'with hope,' rescuers continue searching rubble from NYC explosion; at least 8 dead
Working 'with hope,' rescuers continue searching rubble from NYC explosion; at least 8 dead
Using sound devices to probe for voices and telescopic cameras to peer into small spaces, workers searching a pile of rubble from a gas explosion in New York City continued to treat it Friday as a rescue operation, holding onto the possibility of finding
| Posted: | 10:37 AM on Friday |
| Topic: | Misc World |
| Hits: | 206665 |
| Rating: | 20667 |
| Poster: | Strutz |
 Olympian Clara Hughes launches Big Ride for mental health awareness
Olympian Clara Hughes launches Big Ride for mental health awareness
| Posted: | 10:35 AM on Friday |
| Topic: | Health |
| Hits: | 206768 |
| Rating: | 20678 |
| Poster: | Strutz |
 Russian Foreign Minister Sergey Lavrov: No common vision with U.S. on Ukraine
Russian Foreign Minister Sergey Lavrov: No common vision with U.S. on Ukraine
Russian Foreign Minister Sergey Lavrov said Friday that differences remain between Moscow and the U.S. following negotiations in London aimed at ending the crisis in Ukraine, whose strategic Crimea region is voting this weekend on whether to secede.
| Posted: | 10:34 AM on Friday |
| Topic: | Misc World |
| Hits: | 206639 |
| Rating: | 20664 |
| Poster: | Strutz |
 Disturbing hidden camera video shows abuse at Bright, Ont. turkey farm
Disturbing hidden camera video shows abuse at Bright, Ont. turkey farm
Disturbing video showing employees of one of the world's leading turkey producers clubbing, kicking and otherwise abusing the hapless birds is evidence of a culture of cruelty and neglect at the factory farm, an animal-rights group said Friday.
| Posted: | 10:05 AM on Friday |
| Topic: | Misc CDN |
| Hits: | 206875 |
| Rating: | 20688 |
| Poster: | Strutz |
 Taliban issues congratulations to its forces on 'defeat' of Canadians
Taliban issues congratulations to its forces on 'defeat' of Canadians
A round of goodbye messages are following the last Canadian troops out the door in Afghanistan and some of them are rather nasty. The Taliban's information arm issued a statement Thursday to followers in Kandahar congratulating its fighters in the rural d
| Posted: | 8:55 AM on Friday |
| Topic: | Military |
| Hits: | 207231 |
| Rating: | 20723 |
| Poster: | Robair |
 US gas boom: A tool against Russian coercion
US gas boom: A tool against Russian coercion
The United States, with its abundant supplies of natural gas, would seem to have an easy answer to Europe's fears that a strong response to Russia's rapid takeover of Ukraine's Crimea region could prompt Vladimir Putin to shut down gas lines that keep Eur
| Posted: | 5:15 PM on Thursday |
| Topic: | Business |
| Hits: | 206876 |
| Rating: | 20689 |
| Poster: | N_Fiddledog |
 NSA has 'industrial scale' malware for spying
NSA has 'industrial scale' malware for spying
From Yahoo News: The National Security Agency has developed malware that allows it to collect data automatically from millions of computers worldwide, a report based on leaked documents showed Wednesday.
| Posted: | 3:48 PM on Thursday |
| Topic: | Law & Order |
| Hits: | 206650 |
| Rating: | 20666 |
| Poster: | N_Fiddledog |
 High Arctic adventurer rescued near Taloyoak
High Arctic adventurer rescued near Taloyoak
Vincent Cochin, who was attempting to trek 2,300 kilometres on foot across the High Arctic, had to be rescued Wednesday night near Taloyoak just nine days into his journey.
| Posted: | 2:59 PM on Thursday |
| Topic: | Misc CDN |
| Hits: | 206779 |
| Rating: | 20679 |
| Poster: | Hyack |
 More bureaucrats, departmental lawyers facing life-long gag order
More bureaucrats, departmental lawyers facing life-long gag order
| Posted: | 12:43 PM on Thursday |
| Topic: | Political |
| Hits: | 206804 |
| Rating: | 20681 |
| Poster: | DrCaleb |
 Davis Strait polar bear habitat higher now than in 1979 and early 1980s
Davis Strait polar bear habitat higher now than in 1979 and early 1980s
The Davis Strait polar bear subpopulation is said to be 'vulnerable' to the supposed effects of global warming because, like Hudson Bay, Davis Strait sea ice retreats every summer, leaving polar bears on land for several months. However, Davis Strait bear
| Posted: | 12:24 PM on Thursday |
| Topic: | Environmental |
| Hits: | 206873 |
| Rating: | 20688 |
| Poster: | N_Fiddledog |
 In U.S., Most Do Not See Global Warming as Serious Threat
In U.S., Most Do Not See Global Warming as Serious Threat
Most Americans, 65%, believe global warming is currently happening or will happen in their lifetimes, but far fewer, 36%, predict it will be a serious threat to their way of life.
| Posted: | 11:56 AM on Thursday |
| Topic: | Environmental |
| Hits: | 206922 |
| Rating: | 20693 |
| Poster: | N_Fiddledog |

| Posted: | 11:32 AM on Thursday |
| Topic: | Business |
| Hits: | 206836 |
| Rating: | 20684 |
| Poster: | N_Fiddledog |
 Kidnapped Barcelona girl found in Amazon forest
Kidnapped Barcelona girl found in Amazon forest
A nine-year-old Barcelona girl who went missing seven months ago has been rescued from captivity deep in Bolivia's Amazon rainforest.
| Posted: | 11:31 AM on Thursday |
| Topic: | Law & Order |
| Hits: | 206797 |
| Rating: | 20681 |
| Poster: | N_Fiddledog |
 Environment Canada braces for cuts to climate programs | Toronto Star
Environment Canada braces for cuts to climate programs | Toronto Star
| Posted: | 8:29 AM on Thursday |
| Topic: | Environmental |
| Hits: | 206875 |
| Rating: | 20689 |
| Poster: | DrCaleb |

| Posted: | 8:03 AM on Thursday |
| Topic: | Tech |
| Hits: | 206819 |
| Rating: | 20683 |
| Poster: | QBall |
 Montreal man claims he was attacked after language dispute at Tim Hortons
Montreal man claims he was attacked after language dispute at Tim Hortons
| Posted: | 10:58 PM on Wednesday |
| Topic: | Misc CDN |
| Hits: | 206930 |
| Rating: | 20693 |
| Poster: | Hyack |
 First Nations youth's winter challenge goes viral
First Nations youth's winter challenge goes viral
| Posted: | 10:56 PM on Wednesday |
| Topic: | Misc CDN |
| Hits: | 206705 |
| Rating: | 20671 |
| Poster: | Hyack |
 Father sentenced to 1 year for breaking bones of baby girl
Father sentenced to 1 year for breaking bones of baby girl
A young P.E.I. father who broke the bones of his crying baby has been sentenced to one year in jail.
| Posted: | 10:49 PM on Wednesday |
| Topic: | Law & Order |
| Hits: | 206837 |
| Rating: | 20685 |
| Poster: | Hyack |
 Coast guard warns of bad ice year for Atlantic Canada ships
Coast guard warns of bad ice year for Atlantic Canada ships
The Canadian Coast Guard is pleading with merchant ships to plan their voyages well in advance this year as the organization's icebreaker fleet confronts some of the worst ice conditions on the Atlantic Ocean in decades.
| Posted: | 10:44 PM on Wednesday |
| Topic: | Misc CDN |
| Hits: | 206744 |
| Rating: | 20674 |
| Poster: | Hyack |
 Deep Earth has oceans' worth of water, $10 diamond reveals
Deep Earth has oceans' worth of water, $10 diamond reveals
A dirty, $10 diamond with a prize inside has helped reveal that there are vast quantities of water stored deep inside the Earth.
| Posted: | 10:43 PM on Wednesday |
| Topic: | Science |
| Hits: | 207309 |
| Rating: | 20731 |
| Poster: | Hyack |
 Sea lions rescued from slow death in Fanny Bay, B.C.
Sea lions rescued from slow death in Fanny Bay, B.C.
A Vancouver Aquarium marine mammal rescue team, in partnership with Fisheries and Oceans, has successfully disentangled several California and Stellar sea lions spotted on log booms in the Fanny Bay area of Vancouver Island.
| Posted: | 10:41 PM on Wednesday |
| Topic: | Environmental |
| Hits: | 206818 |
| Rating: | 20683 |
| Poster: | Hyack |
 9 Shilo soldiers injured after military trucks collide
9 Shilo soldiers injured after military trucks collide
Nine Canadian Forces soldiers were sent to hospital after two military trucks collided at CFB Shilo in western Manitoba on Wednesday evening.
| Posted: | 10:21 PM on Wednesday |
| Topic: | Military |
| Hits: | 207130 |
| Rating: | 20713 |
| Poster: | Hyack |
 Canucks edge Jets in shootout, lose Ryan Kesler
Canucks edge Jets in shootout, lose Ryan Kesler
Chris Higgins had the only goal in the shootout as the Vancouver Canucks handed the Winnipeg Jets their fifth straight loss with a 3-2 victory on Wednesday night.
| Posted: | 9:24 PM on Wednesday |
| Topic: | Sports |
| Hits: | 206674 |
| Rating: | 20667 |
| Poster: | Hyack |
 Ikea looking for employee who called breastfeeding mother 'disgusting'
Ikea looking for employee who called breastfeeding mother 'disgusting'
| Posted: | 6:40 PM on Wednesday |
| Topic: | Misc CDN |
| Hits: | 206961 |
| Rating: | 20696 |
| Poster: | Hyack |
 Tim Hortons server kicks out London, Ont. paraplegic man because of electric wheelchair
Tim Hortons server kicks out London, Ont. paraplegic man because of electric wheelchair
A London, Ont. man says he was humiliated after being kicked out of a Tim Hortons because of his three-wheeled scooter wheelchair.
| Posted: | 6:38 PM on Wednesday |
| Topic: | Misc CDN |
| Hits: | 206945 |
| Rating: | 20695 |
| Poster: | Hyack |
 Richard Kennedy admits 'homophobic attack' was made up
Richard Kennedy admits 'homophobic attack' was made up
WARNING: GRAPHIC CONTENT Richard Kennedy, 18, from Blackpool, suffered dislodged teeth, a bad knee injury and a swollen face after he left the Evoque nightclub in Preston, Lancashire, in the early hours of the morning.
| Posted: | 2:58 PM on Wednesday |
| Topic: | Lifestyle |
| Hits: | 207074 |
| Rating: | 20707 |
| Poster: | N_Fiddledog |
 European Union wants to force the U.S. to rename products like Parmesan cheese
European Union wants to force the U.S. to rename products like Parmesan cheese
The EU says American-made feta, gorgonzola, Parmesan and other products aren't fit to be called by their traditional names.
| Posted: | 2:50 PM on Wednesday |
| Topic: | Business |
| Hits: | 207151 |
| Rating: | 20715 |
| Poster: | N_Fiddledog |
 Olivia Chow resigns seat, set to launch Toronto mayoral bid
Olivia Chow resigns seat, set to launch Toronto mayoral bid
A senior source in her campaign told The Globe the federal MP will resign her seat in Parliament Wednesday and kick off her campaign Thursday
| Posted: | 2:24 PM on Wednesday |
| Topic: | Political |
| Hits: | 206933 |
| Rating: | 20693 |
| Poster: | N_Fiddledog |
 Harper picked two beers to represent Canada. Here's what he chose
Harper picked two beers to represent Canada. Here's what he chose
Harper agreed to a wager with U.S. President Obama on the outcome of two Olympic hockey games. The Prime Minister's choice was revealed Tuesday
| Posted: | 12:03 PM on Wednesday |
| Topic: | Sports |
| Hits: | 206863 |
| Rating: | 20686 |
| Poster: | DrCaleb |
 Alberta legislature too disrespectful for school visits
Alberta legislature too disrespectful for school visits
Teachers at a middle school in Innisfail will no longer take their students to question period at the Alberta legislature after they witnessed the poor behaviour of the members there during a session last fall.
| Posted: | 10:17 AM on Wednesday |
| Topic: | Provincial Politics |
| Hits: | 206965 |
| Rating: | 20697 |
| Poster: | DrCaleb |
 Ross River residents block access to river to save bridge
Ross River residents block access to river to save bridge
People in Ross River, Yukon, have gathered on the ice of the Pelly River, vowing to stop any demolition work on the historic suspension bridge there.
| Posted: | 10:17 AM on Wednesday |
| Topic: | Misc CDN |
| Hits: | 206746 |
| Rating: | 20675 |
| Poster: | DrCaleb |
 World Science University wants to teach you physics for free
World Science University wants to teach you physics for free
With online lectures, MOOCs, and open courseware, it's probably never been easier to get access to college-level instruction on a huge variety of topics. But yesterday saw the launch of a new entry dedicated to scientific concepts: the World Science Unive
| Posted: | 8:14 AM on Wednesday |
| Topic: | Science |
| Hits: | 207180 |
| Rating: | 20718 |
| Poster: | DrCaleb |
 London economist searching for meaning of cryptic note he found at Western University library
London economist searching for meaning of cryptic note he found at Western University library
| Posted: | 7:58 AM on Wednesday |
| Topic: | Strange |
| Hits: | 206817 |
| Rating: | 20682 |
| Poster: | DrCaleb |
 Food industry reinvents itself amid shutdowns, lost jobs
Food industry reinvents itself amid shutdowns, lost jobs
| Posted: | 7:53 AM on Wednesday |
| Topic: | Business |
| Hits: | 206729 |
| Rating: | 20673 |
| Poster: | DrCaleb |
 U.S. man who spent 26 years on death row freed | CTV News
U.S. man who spent 26 years on death row freed | CTV News
A man who spent nearly 26 years on death row in Louisiana walked free of prison Tuesday, hours after a judge approved the state's motion to vacate the man's murder conviction in a the 1983 killing of a jeweler.
| Posted: | 7:52 AM on Wednesday |
| Topic: | Law & Order |
| Hits: | 206723 |
| Rating: | 20672 |
| Poster: | DrCaleb |
 Canadian soldiers in Afghanistan: a video timeline
Canadian soldiers in Afghanistan: a video timeline
As Canada officially ends its engagement in Afghanistan, which started in 2002, CBC News takes a look back at the most memorable moments of this highly controversial mission.
| Posted: | 3:17 PM on Tuesday |
| Topic: | Military |
| Hits: | 207365 |
| Rating: | 20737 |
| Poster: | Canadaka |
 Putin's Man in Crimea Sergei Aksyonov Is Ukraine's Worst Nightmare
Putin's Man in Crimea Sergei Aksyonov Is Ukraine's Worst Nightmare
Little is known about Sergei Aksyonov, the pro-Russia Crimean leader, who rose from obscurity in a month and who is driving the region toward secession
| Posted: | 1:33 PM on Tuesday |
| Topic: | Misc World |
| Hits: | 206752 |
| Rating: | 20675 |
| Poster: | N_Fiddledog |
 Pauline Marois says independent Quebec would have no borders or tolls
Pauline Marois says independent Quebec would have no borders or tolls
| Posted: | 1:30 PM on Tuesday |
| Topic: | Provincial Politics |
| Hits: | 207094 |
| Rating: | 20709 |
| Poster: | DrCaleb |
 Price of new hepatitis C drug questioned by U.S. medical experts
Price of new hepatitis C drug questioned by U.S. medical experts
An innovative hepatitis C drug that was only recently hailed as a breakthrough treatment is facing skepticism from some health care providers, as they consider whether it is worth the $1,000-a-pill price set by manufacturer Gilead Sciences Inc.
| Posted: | 1:28 PM on Tuesday |
| Topic: | Health |
| Hits: | 206833 |
| Rating: | 20684 |
| Poster: | DrCaleb |
 Nunavut prison report censored for no reason, watchdog says
Nunavut prison report censored for no reason, watchdog says
Nunavut's information watchdog says she's found no reason why the territory's justice department refuses to release a report about conditions at the Baffin Correctional Centre. She says problems at the prison are already widely known.
| Posted: | 1:28 PM on Tuesday |
| Topic: | Law & Order |
| Hits: | 206672 |
| Rating: | 20668 |
| Poster: | DrCaleb |
 Caribbean leaders are to sue Britain for its part in the slave trade
Caribbean leaders are to sue Britain for its part in the slave trade
A coalition of Caribbean leaders will meet today in St. Vincent to discuss a landmark legal claim for reparations - that could run into the hundreds of billions of pounds.
| Posted: | 9:47 AM on Tuesday |
| Topic: | Law & Order |
| Hits: | 207032 |
| Rating: | 20703 |
| Poster: | N_Fiddledog |
 22-pound house cat attacks baby, traps owners in bedroom | CTV News
22-pound house cat attacks baby, traps owners in bedroom | CTV News
Portland police had to be called in to subdue a 22-pound (10-kilogram) house cat that trapped its owners inside their bedroom after attacking their baby. The baby was not injured in the Sunday incident.
| Posted: | 9:26 AM on Tuesday |
| Topic: | Law & Order |
| Hits: | 206872 |
| Rating: | 20688 |
| Poster: | DonnaWho |
 Iraqi women protest against proposed Islamic law in Iraq
Iraqi women protest against proposed Islamic law in Iraq
BAGHDAD (Reuters) - About two dozen Iraqi women demonstrated on Saturday in Baghdad against a draft law approved by the Iraqi cabinet that would permit the marriage of nine-year-old girls and automatically give child custody to fathers.
| Posted: | 9:20 AM on Tuesday |
| Topic: | Religion |
| Hits: | 207364 |
| Rating: | 20737 |
| Poster: | N_Fiddledog |
 Why Do 16th-Century Manuscripts Show Cats With Flaming Backpacks?
Why Do 16th-Century Manuscripts Show Cats With Flaming Backpacks?
Illustrations in 16th-century artillery manuals show how to use cats to attack a city.
| Posted: | 8:45 AM on Tuesday |
| Topic: | History |
| Hits: | 206885 |
| Rating: | 20690 |
| Poster: | DonnaWho |
As many as 100 kids in Fraser Valley, B.C. may have measles | CTV News
As many as 100 kids in Fraser Valley, B.C. may have measles | CTV News
Two unvaccinated children in B.C.'s Fraser Valley have contracted the extremely contagious measles virus, putting others in the community at risk.
| Posted: | 8:01 AM on Tuesday |
| Topic: | Health |
| Hits: | 206862 |
| Rating: | 20687 |
| Poster: | DrCaleb |
 Jock VI: Latest orange cat lands at Winston Churchill's estate | CTV News
Jock VI: Latest orange cat lands at Winston Churchill's estate | CTV News
There is a new kitten at the Winston Churchill estate. The orange-colored rescue cat is there to comply with the late British leader's request that there always be a cat of that colour living at Chartwell.
| Posted: | 7:06 AM on Tuesday |
| Topic: | Misc World |
| Hits: | 206906 |
| Rating: | 20693 |
| Poster: | stemmer |
 Opinion: Swimming in a sea of disinformation over the Great Barrier Reef
Opinion: Swimming in a sea of disinformation over the Great Barrier Reef
| Posted: | 3:33 PM on Monday |
| Topic: | Environmental |
| Hits: | 206888 |
| Rating: | 20690 |
| Poster: | N_Fiddledog |
 Ukraine clashes see Russian activists attack pro-Kiev rally in Crimea, Sevastopol
Ukraine clashes see Russian activists attack pro-Kiev rally in Crimea, Sevastopol
| Posted: | 3:22 PM on Monday |
| Topic: | Misc World |
| Hits: | 206870 |
| Rating: | 20688 |
| Poster: | N_Fiddledog |

Censors for Qatar, Bahrain and UAE said it went against the teachings of Islam and Cairo's Al-Azhar, a Sunni institution more than 1,000 years old, said it objected to any depictions of God's messengers.
| Posted: | 3:03 PM on Monday |
| Topic: | Arts & Entertainment |
| Hits: | 207103 |
| Rating: | 20710 |
| Poster: | N_Fiddledog |
 Obama administration pollutes guidelines for healthy eating with unhealthy ideologies | WashingtonExaminer.com
Obama administration pollutes guidelines for healthy eating with unhealthy ideologies | WashingtonExaminer.com
When Big Food and Big Food Police congratulate each other for coming together with the White House, as they did when new food nutrition labels were unveiled last week, consumers and small businesses should be very nervous. But the controversial new label
| Posted: | 3:01 PM on Monday |
| Topic: | Uncle Sam |
| Hits: | 206840 |
| Rating: | 20685 |
| Poster: | N_Fiddledog |
 Sarah Palin pursued as host at streaming network | New York Post
Sarah Palin pursued as host at streaming network | New York Post
Sarah Palin is being wooed by two news media veterans to join a streaming network, The Post has learned.
| Posted: | 2:51 PM on Monday |
| Topic: | Business |
| Hits: | 206894 |
| Rating: | 20690 |
| Poster: | N_Fiddledog |
 Sharyl Attkisson resigns from CBS News
Sharyl Attkisson resigns from CBS News
CBS News investigative correspondent Sharyl Attkisson has reached an agreement to resign from CBS News ahead of contract, bringing an end to months of hard-fought negotiations, sources familiar with her departure told POLITICO on Monday. Attkisson, who ha
| Posted: | 2:23 PM on Monday |
| Topic: | Political |
| Hits: | 206838 |
| Rating: | 20685 |
| Poster: | N_Fiddledog |
 Atheists want iconic 17-foot cross removed from 9/11 museum
Atheists want iconic 17-foot cross removed from 9/11 museum
| Posted: | 12:22 PM on Monday |
| Topic: | Uncle Sam |
| Hits: | 208039 |
| Rating: | 20805 |
| Poster: | N_Fiddledog |
 Jihadi Crimean Tatars Threaten Terrorism After Russian Takeover | Business Insider
Jihadi Crimean Tatars Threaten Terrorism After Russian Takeover | Business Insider
| Posted: | 12:14 PM on Monday |
| Topic: | Misc World |
| Hits: | 206891 |
| Rating: | 20689 |
| Poster: | N_Fiddledog |
 North Korea's Kim Jong-un gets 100% of 'yes' votes in election
North Korea's Kim Jong-un gets 100% of 'yes' votes in election
With no one else on the ballot, state media reported Monday that supreme leader Kim Jong-un was not only elected to the highest legislative body in North Korea, he won with the unanimous approval of his district, which had 100 per cent turnout.
| Posted: | 11:00 AM on Monday |
| Topic: | Misc World |
| Hits: | 206724 |
| Rating: | 20672 |
| Poster: | DrCaleb |
 Blues climb to top of the NHL heap
Blues climb to top of the NHL heap
Elliott, Oshie star in shootout win over Minnesota.
| Posted: | 4:02 AM on Monday |
| Topic: | Sports |
| Hits: | 206782 |
| Rating: | 20678 |
| Poster: | stemmer |
 Bulgarian police recover DNA evidence of one of Burgas bombers | JPost | Israel News
Bulgarian police recover DNA evidence of one of Burgas bombers | JPost | Israel News
Hezbollah operative who remotely detonated bomb in suicide bomber's backpack left hats, towel in hotel room which yield DNA evidence.
| Posted: | 12:07 PM on Sunday |
| Topic: | Lifestyle |
| Hits: | 206790 |
| Rating: | 20679 |
| Poster: | N_Fiddledog |
 'Hip hop jihadist' claims he was kidnapped, tortured and robbed by fellow Islamists
'Hip hop jihadist' claims he was kidnapped, tortured and robbed by fellow Islamists
| Posted: | 12:05 PM on Sunday |
| Topic: | Misc World |
| Hits: | 207860 |
| Rating: | 20786 |
| Poster: | N_Fiddledog |
 Canucks win!!
Canucks win!!
Defenceman Yannick Weber scored the go-ahead goal early in the third period as the Vancouver Canucks breathed a sigh of relief with a 2-1 win over the Calgary Flames on the Saturday night.
| Posted: | 10:30 PM on Saturday |
| Topic: | Sports |
| Hits: | 206734 |
| Rating: | 20673 |
| Poster: | Hyack |
 Clocks spring forward Sunday for daylight saving time
Clocks spring forward Sunday for daylight saving time
Most Canadians will be moving their clocks forward an hour on Sunday for the switch from local standard time back to daylight saving time for the summer months. Here are six interesting facts about daylight savings.
| Posted: | 5:02 PM on Saturday |
| Topic: | Misc CDN |
| Hits: | 206783 |
| Rating: | 20678 |
| Poster: | Hyack |
 Ukrainian computers infected by powerful virus
Ukrainian computers infected by powerful virus
Stuxnet-like malware attacking systems in embroiled state; experts suspect Russian involvement
| Posted: | 3:17 PM on Saturday |
| Topic: | Tech |
| Hits: | 206982 |
| Rating: | 20698 |
| Poster: | N_Fiddledog |
 Canada day terrorism trial set to start January 2015
Canada day terrorism trial set to start January 2015
VANCOUVER - A British Columbia couple accused of a Canada Day bomb plot at the provincial legislature are scheduled to stand trial for more than three months beginning in January of next year. . . .
| Posted: | 10:44 AM on Saturday |
| Topic: | Law & Order |
| Hits: | 206783 |
| Rating: | 20678 |
| Poster: | N_Fiddledog |
 Fireball explodes over Yellowknife
Fireball explodes over Yellowknife
A fireball exploded and lit up the skies over Yellowknife early Thursday morning, but was not believed to have caused any damage. The exploding meteor was described as being so bright that it turned the night sky blue.
| Posted: | 11:41 PM on Friday |
| Topic: | Misc World |
| Hits: | 206856 |
| Rating: | 20686 |
| Poster: | Hyack |
 DND announces DEW Line clean-up completed
DND announces DEW Line clean-up completed
The DEW Line remediation project cost the government $575 million and saw the removal of toxic waste from 21 former radar stations across the Arctic.
| Posted: | 11:36 PM on Friday |
| Topic: | Environmental |
| Hits: | 206917 |
| Rating: | 20692 |
| Poster: | Hyack |
 Vic Toews appointed judge in Manitoba
Vic Toews appointed judge in Manitoba
Former public safety minister Vic Toews, who retired from politics last year, has been appointed a judge in the Court of Queen's Bench in Manitoba.
| Posted: | 10:20 AM on Friday |
| Topic: | Law & Order |
| Hits: | 206819 |
| Rating: | 20682 |
| Poster: | DrCaleb |
 Teen energy drink consumption linked to depression and substance abuse
Teen energy drink consumption linked to depression and substance abuse
Consumption of high-caffeine energy drinks among high school students may be linked with mental health issues and substance use, says a new report, which calls for limits on teens' access to the beverages and reduction in the amount of caffeine they conta
| Posted: | 8:30 AM on Friday |
| Topic: | Health |
| Hits: | 206835 |
| Rating: | 20685 |
| Poster: | DrCaleb |
 Canada-South Korea trade deal appears close after decade of talks
Canada-South Korea trade deal appears close after decade of talks
The Harper government is set to sign a long-sought trade deal with South Korea early next week, despite entrenched opposition by some in Ontario's critically important auto sector, sources close to the talks say.
| Posted: | 7:24 AM on Friday |
| Topic: | Business |
| Hits: | 206722 |
| Rating: | 20672 |
| Poster: | DrCaleb |
 Federal action on grain backlog to be announced today
Federal action on grain backlog to be announced today
The question of what Ottawa is prepared to do about the huge backlog of Prairie grain could be answered later this morning. Transport Minister Lisa Raitt and Agriculture Minister Gerry Ritz are set to make an announcement at 10:30 CT in Winnipeg "to addre
| Posted: | 7:17 AM on Friday |
| Topic: | Business |
| Hits: | 206691 |
| Rating: | 20669 |
| Poster: | DrCaleb |
 Daycare suspends 2-year-old girl over cheese sandwich
Daycare suspends 2-year-old girl over cheese sandwich
An Ottawa father is looking to move his children out of their daycare over its strict "no outside food" policy, after his daughter was suspended for three days for bringing a cheese sandwich to class.
| Posted: | 9:23 PM on Thursday |
| Topic: | Misc CDN |
| Hits: | 206815 |
| Rating: | 20682 |
| Poster: | Hyack |
 York University shooting injures 2
York University shooting injures 2
Two women suffered non-life threatening injuries when they were shot on York University campus in Toronto on Thursday night, emergency officials say.
| Posted: | 9:22 PM on Thursday |
| Topic: | Misc CDN |
| Hits: | 206715 |
| Rating: | 20672 |
| Poster: | Hyack |
 Royal Canadian Legion to call for better care of wounded vets
Royal Canadian Legion to call for better care of wounded vets
The Royal Canadian Legion is set to call on the Harper government to take better care of wounded veterans and their families.
| Posted: | 9:19 PM on Thursday |
| Topic: | Misc CDN |
| Hits: | 206633 |
| Rating: | 20663 |
| Poster: | Hyack |
 New smartphone app wakes you up with smell of bacon
New smartphone app wakes you up with smell of bacon
| Posted: | 11:40 AM on Thursday |
| Topic: | Funny |
| Hits: | 207795 |
| Rating: | 20780 |
| Poster: | DrCaleb |
 Wheat board could have helped move grain, NDP MP Pat Martin says
Wheat board could have helped move grain, NDP MP Pat Martin says
A major grain backlog would have been easier to manage if the Canadian Wheat Board was still able to co-ordinate grain transportation for Prairie wheat, New Democrat MP Pat Martin says.
| Posted: | 11:27 AM on Thursday |
| Topic: | Business |
| Hits: | 206879 |
| Rating: | 20689 |
| Poster: | DrCaleb |
 Harper, world leaders reject proposed Crimean referendum
Harper, world leaders reject proposed Crimean referendum
The Canadian government joined the German and U.S. governments in rejecting the legitimacy of the referendum, saying it will not recognize the results. The parliament in Crimea, which enjoys a degree of autonomy under current Ukrainian law, voted 78 with
| Posted: | 10:40 AM on Thursday |
| Topic: | Misc World |
| Hits: | 206750 |
| Rating: | 20675 |
| Poster: | DrCaleb |
 Election chief Marc Mayrand warns of holes in election act
Election chief Marc Mayrand warns of holes in election act
Canada's "level playing field" may be compromised under changes proposed in the Conservatives' election reform bill, Chief Electoral Officer Marc Mayrand warned Thursday. "In Canada, electoral fairness has traditionally been understood to mean maintain
| Posted: | 10:04 AM on Thursday |
| Topic: | Law & Order |
| Hits: | 206738 |
| Rating: | 20674 |
| Poster: | DrCaleb |
 Shannon Szabados takes gold medal form to Oilers practice
Shannon Szabados takes gold medal form to Oilers practice
Talk at the Edmonton Oilers practice today wasn't just about who was coming and going as the trade deadline loomed, but who was in net. "Just another player on the ice with just a little longer hair than the rest of them," laughed Canadian women's hockey
| Posted: | 8:28 AM on Thursday |
| Topic: | Sports |
| Hits: | 206733 |
| Rating: | 20673 |
| Poster: | DrCaleb |
The comments are property of their posters, all the rest © 2026 by Canadaka.net

